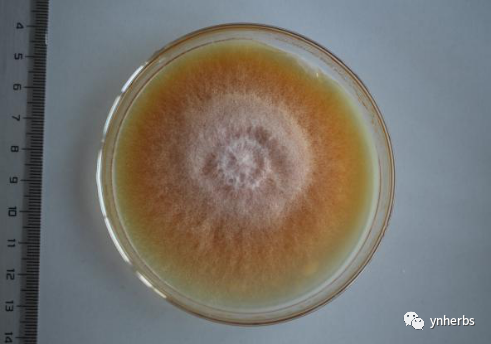
17.png

纳板河流域国家级自然保护区(以下简称纳板河保护区) 是我国第一个按小流域生物圈保护理念规划建设的多功能、综合型自然保护区。1991 年7月建立,2000年4月晋升为国家级自然保护区,位于云南省南部、西双版纳傣族自治州中北部,地跨景洪和勐海县,以澜沧江、湄公河的一级支流纳板河流域范围为界,总面积26666公顷,其中核心区3900 公顷、缓冲区5808公顷、实验区16892公顷。保护区地势西北高,东南低,最高海拔2304米,最低海拔539米,自然条件复杂,立体气候明显,年降雨量1100-1600毫米,年平均气温18-22℃,热量丰富,雨量充沛。土壤类型主要有砖红壤、赤红壤、红壤、黄壤。
纳板河保护区作为“中国西南山地”的重要组成部分被列入“全球生物多样性热点地区”,在《中国生物多样性保护行动计划》中列为我国优先保护生态系统与物种的关键地区之一。现已知保护区内有高等植物2945种或变种,隶属291科1220属,其中有篦齿苏铁、刺桫椤、疣粒野生稻等国家重点保护野生植物21种;有脊椎动物437种,其中有孔雀雉、豹、印度野牛等国家重点保护野生动物68种。保护区拥有8种植被类型、13种植被亚型、28个群系,可谓种类繁多,各具风采,尤其是拥有珍贵的热带雨林生态系统,被誉为“镶嵌在热带北缘上的一颗“璀璨明珠”。

图1 纳板河保护区功能分区图及高程模型图
尽管纳板河保护区生物多样性高,物种丰富,而关于该区的虫草资源调查却罕见报道,因此为探明纳板河保护区虫草生物多样性及其分布,促进纳板河保护区虫草生物多样性保护与可持续利用,2020年8月15日-2020年8月17日,bat365中文官方网站——中国(云南)东南亚虫草生物资源可持续利用国际联合研究中心(The International Joint Research Center for Sustainable Utilization of Cordyceps Bioresources in China and Southeast Asia),对纳板河保护区进行虫草生物资源调查,参与调查的主要成员有bat365中文官方网站虞泓教授,博士研究生汤德相,硕士研究生赵志远、王志勤、吴慧娟、邹维秋及王耀民,云南云百草实验室杨实道和李东伟,昆明琛龙汽车租赁有限公司刘敏和杨永楷师傅。

图2 纳板河保护区虫草生境
表1 纳板河保护区虫草样地信息
样地名称 | 经度 | 纬度 | 海拔 |
曼点村 | 100°66′28″ | 22°13′02″ | 722m |
曼吕村 | 100°68′76″ | 22°14′17″ | 603m |
五七队 | 100°70′64″ | 22°13′93″ | 602m |

图3 虞泓教授虫草研究团队在曼点村调查采集虫草

图4 虞泓教授虫草研究团队在曼吕村调查采集虫草
经过为期三天的虫草资源调查,共调查采集虫草标本200余份,记3科4属14种(见表2),其中优势种为线虫草科(Ophiocordycipitaceae)线虫草属(Ophiocordyceps),寄主主要有半翅目、膜翅目、鳞翅目,具体如下:
表2 虫草物种信息统计表
Families | Number | Species | Host |
Ophiocordycipitaceae | 1 | Ophiocordyceps nutans | Hemiptera |
2 | Ophiocordyceps sp.01 | Blattaria | |
3 | Ophiocordyceps sp.02 | Hymenoptera | |
4 | Ophiocordyceps sp.03 | Hymenoptera | |
5 | Ophiocordyceps sp.04 | Hymenoptera | |
6 | Ophiocordyceps sp.05 | Hymenoptera | |
7 | Ophiocordyceps mymecophila | Hymenoptera | |
8 | Ophiocordyceps sp.06 | Hemiptera | |
Cordycipitaceae | 1 | Beauveria bassiana | Coleoptera |
2 | Cordyceps pruinosa | Lepidoptera | |
3 | Cordyceps sp.01 | Araneae | |
4 | Cordyceps tenuipes | Lepidoptera | |
5 | Cordyceps sp.02 | Lepidoptera | |
Clavicipitaceae | 1 | Aschersonia sp.01 | Homoptera |
1线虫草科Ophiocordycipitaceae
1.1线虫草属Ophiocordyceps
1.1.1垂头虫草Ophiocordyceps nutans
寄主:半翅目(椿象)
生境:生于常绿阔叶林或针阔混交林

图5 Ophiocordyceps nutans
1.1.2 Ophiocordyceps sp.01
寄主:蜚蠊目(蟑螂)
生境:生于常绿阔叶林

图6 Ophiocordyceps sp.01
1.1.3 Ophiocordyceps sp.02
寄主:膜翅目(蚂蚁)
生境:生于常绿阔叶林或针阔混交林一种蚂蚁上

图7 Ophiocordyceps sp.02
1.1.4 Ophiocordyceps sp.03
寄主:膜翅目(蚂蚁)
生境:生于常绿阔叶林或针阔混交林一种蚂蚁上

图8 Ophiocordyceps sp.03
1.1.5 Ophiocordyceps sp.04
寄主:膜翅目(蚂蚁)
生境:生于常绿阔叶林或针阔混交林一种蚂蚁上

图9 Ophiocordyceps sp.04
1.1.6 Ophiocordyceps sp.05
寄主:膜翅目(蚂蚁)
生境:生于常绿阔叶林或针阔混交林一种蚂蚁上

图10 Ophiocordyceps sp.05
1.1.7 Ophiocordyceps mymecophila
寄主:膜翅目(蚂蚁)
生境:生于常绿阔叶林或针阔混交林一种蚂蚁上

图11 Ophiocordyceps mymecophila
1.1.8 Ophiocordyceps sp.06
寄主:半翅目(蝉若虫)
生境:生于常绿阔叶林或针阔混交林蝉成虫上

图12 Ophiocordyceps sp.06
2虫草科
2.1白僵菌属Beauveria
2.1.1球孢白僵菌Beauveria bassiana
寄主:鞘翅目
生境:生于常绿阔叶林或针阔混交林

图13 Beauveria bassiana
2.2虫草属Cordyceps Fr.
2.2.1粉被虫草Cordyceps pruinosa
寄主:鳞翅目(刺蛾蛹)
生境:生于常绿阔叶林鳞翅目昆虫幼虫上

图14 Cordyceps pruinosa
2.2.2 Cordyceps sp.01
寄主:蜘蛛目(蜘蛛)
生境:生于常绿阔叶林土壤层石缝中

图15 Cordyceps sp.01
2.2.3 Cordyceps tenuipes
寄主:鳞翅目
生境:常绿阔叶林或灌丛地

图16 Cordyceps tenuipes
2.2.4 Cordyceps sp.02
寄主:鳞翅目蛹
生境:常绿阔叶林
图17 Cordyceps sp.02
3麦角菌科Clavicipitaceae
3.1座壳孢属Aschersonia
3.1.1 Aschersonia sp.01
寄主:同翅目(介壳虫或粉虱)
生境:常绿阔叶林

图18 Aschersonia sp.01
此次纳板河保护区虫草资源调查第一天晚上,调查团队还在护林员的带领下观看纳板河保护区的纪录片,参观纳板河保护区的沙盘,学习了解纳板河保护区各类国家重点保护野生动植物。

图19 虞泓教授讲解介绍纳板河保护区沙盘

图20 调查团队学习认识纳板河保护区珍稀动植物
总的来说,纳板河保护区各类动植物资源极其丰富,尤其是虫草生物多样性十分丰富,发现保护区具有适宜虫草生长的生态环境,虫草物种多样性特别丰富;同时初步了解了纳板河保护区草资源分布情况,为纳板河保护区虫草生物多样性保护与可持续利用提供了第一手资料。
致 谢
此次bat365中文官方网站虞泓教授虫草研究团队前往纳板河保护区调查虫草资源,感谢纳板河保护区管理局李忠清、刘峰、保护区护林员杨家有及其家人在生活上给予的帮助与支持,为此次纳板河保护区虫草资源调查提供了保障和帮助,感谢昆明琛龙汽车租赁有限公司刘敏和杨永楷师傅,使得整个调查工作顺利进行,成果颇丰。